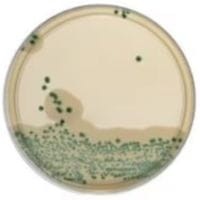
Brilliance_Listeria_Agar_Plates_gotowa_pożywka_do_oznaczania_Listeria_Bestlabs.jpg

Brilliance Listeria Agar gotowa pożywka do oznaczania Listeria
• Opakowanie: 10 szt.
• Płytka: 90 mm.
• Do oznaczania: Listeria i L. monocytogenes
 Opis
Opis
Brilliance™ Listeria Agar Plates to wysokiej jakości gotowe podłoże mikrobiologiczne, opracowane do identyfikacji i różnicowania bakterii z rodzaju Listeria, w tym Listeria monocytogenes. Dzięki zastosowaniu technologii opartej na X-glukozydzie i lecytynazy, pożywka umożliwia szybką i precyzyjną analizę mikrobiologiczną próbek.
Cechy i zalety produktu
Szybka identyfikacja
- Wykorzystanie X-glukozydu pozwala na wizualne oznaczenie bakterii Listeria poprzez niebiesko-zielone kolonie.
- Listeria monocytogenes jest różnicowana dzięki zdolności do produkcji lecytynazy, co prowadzi do powstania charakterystycznej białej, nieprzezroczystej aureoli wokół kolonii.
Gotowość do użycia
- Gotowe płytki agarowe eliminują potrzebę przygotowywania pożywek, co oszczędza czas i minimalizuje ryzyko błędów laboratoryjnych.
- Standardowa wielkość płytki: 90 mm, odpowiednia do standardowych procedur mikrobiologicznych.
Wydajne pakowanie
- Opakowanie 10 sztuk – idealne rozwiązanie dla laboratoriów o średnim zapotrzebowaniu na analizy.
Specyfikacja produktu
- Typ pożywki: Brilliance™ Listeria Agar.
- Do oznaczania: Listeria spp. i Listeria monocytogenes.
- Płytka: 90 mm.
- Opakowanie: 10 szt.
Zastosowanie
Brilliance™ Listeria Agar Plates sprawdzają się w:
- Badaniach mikrobiologicznych żywności – wykrywanie i identyfikacja Listeria w próbkach spożywczych.
- Kontroli jakości w przemyśle spożywczym – ocena obecności patogenów w procesach produkcyjnych.
- Badaniach klinicznych – analiza próbek biologicznych w diagnostyce laboratoryjnej.
Dlaczego warto wybrać Brilliance™ Listeria Agar Plates?
Kluczowe korzyści:
- Precyzja – wizualna identyfikacja i różnicowanie Listeria spp. dzięki technologii X-glukozydu i lecytynazy.
- Wygoda – gotowe do użycia płytki agarowe eliminują konieczność przygotowywania pożywek.
- Wydajność – opakowanie 10 sztuk idealnie odpowiada potrzebom standardowych analiz laboratoryjnych.
Brilliance™ Listeria Agar Plates to niezawodne rozwiązanie dla laboratoriów mikrobiologicznych, które wymagają precyzyjnych i wygodnych narzędzi do analizy próbek na obecność bakterii Listeria.
W powyższym linku znajdą Państwo bazę aktualnych certyfikatów firmy OXOID. Wystarczy wpisać numer LOT zamówionej przez Państwa partii, w celu uzyskania odpowiedniego certyfikatu.
 Koszty dostawy
Cena netto, nie zawiera podatku
Koszty dostawy
Cena netto, nie zawiera podatku
darmowa i wygodna wysyłka
już od 800 zł netto
Najwyższa jakość
produktów potwierdzona certyfikatami
Zakupy 24h na dobę
wygodne i bezpieczne
bezpłatna konsultacja
z ekspertem online